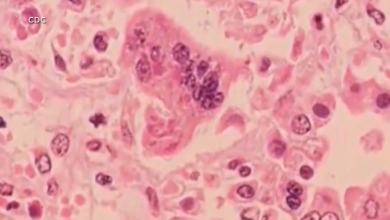
57 cases of measles confirmed at Ave Maria University, 7 currently contagious

Masters of the Universe has quite the roster of classic characters, and a host of them will be making an appearance in the anticipated live-action film. Even just looking at the last trailer saw appearances from characters like Mekaneck, Ram Man, and Trap Jaw in addition to He-Man, Skeletor, and the rest of the main team. It appears that the film will also feature some even deeper cuts though, including two of the weirdest villains in He-Man history.
Videos by ComicBook.com
Mattel Creations’ Brick Shop revealed its Masters of the Universe: Clash at Snake Mountain Building Set, and the description indicates it is based on the battle between the Heroes of Eternia and Skeletor from the film. The set also includes 12 NanoWorld figures to help recreate that battle, and while it includes multiple characters we’ve already seen in footage, it also includes Pig Boy, Karg, and Gygor, which are deep cuts that no one would have expected to make an appearance.

No One Expected These Characters To Make The Cut In The Masters of the Universe Reboot


Not one of these three characters would have been predicted to make the cut in a Masters of the Universe reboot, but it appears that all three will make it to the big screen, and one of the characters will make it there for the very first time.
Let’s start with Karg, who was a completely new character that was created for the 1987 Masters of the Universe live-action film. Karg was originally played by Robert Towers, and his grizzled face and high hair make him pretty hard to miss. The character has a hook for one of his hands and is a high-ranking commander in Skeletor’s army. This new design keeps the hook hand but does tone down the hair and gives the character a more militarized costume as well.
Next up is Gygor, who was actually an unreleased character from the Masters of the Universe toyline. The gladiator gorilla would eventually receive a figure in the Masters of the Universe Classics line, and that’s when he also received his first bio, which revealed that after several unsuccessful raids on Castle Grayskull, he was put in suspended animation, only to be freed by Evil-Lyn. The character keeps his yellow and green color scheme from the toy, too, so it appears we’ll get a toy-accurate version in the movie as well.


Finally, there’s Pig Boy, who was a character in the 1987 Masters of the Universe live-action film like Karg, but Pig Boy has a more interesting story attached. The person who played Pig Boy in the film was named Richard Szponder, and he actually won a contest when he was eight years old that gave him the chance to be in the Masters of the Universe film. Pig Boy is one of Skeletor’s minions in the film and often carries Skeletor’s Havoc staff. It appears a modern version of the character will appear in the new film as well, and you can also get him as part of this set.
As for the Snake Mountain Set itself, it retails for $54.00, and you can find the official description right here. “The sinister Snake Mountain stands tall in this detailed set by Mattel Brick Shop. Recreate the battle between the Heroes of Eternia and Skeletor, complete with 12 NanoWorld figures, special effects, and authentic details. The clash of good and evil is yours to build and display. Collect all the Masters of the Universe building sets by Mattel Brick Shop and build the movie; each sold separately.”
What do you think? Leave a comment below and join the conversation now in the ComicBook Forum!